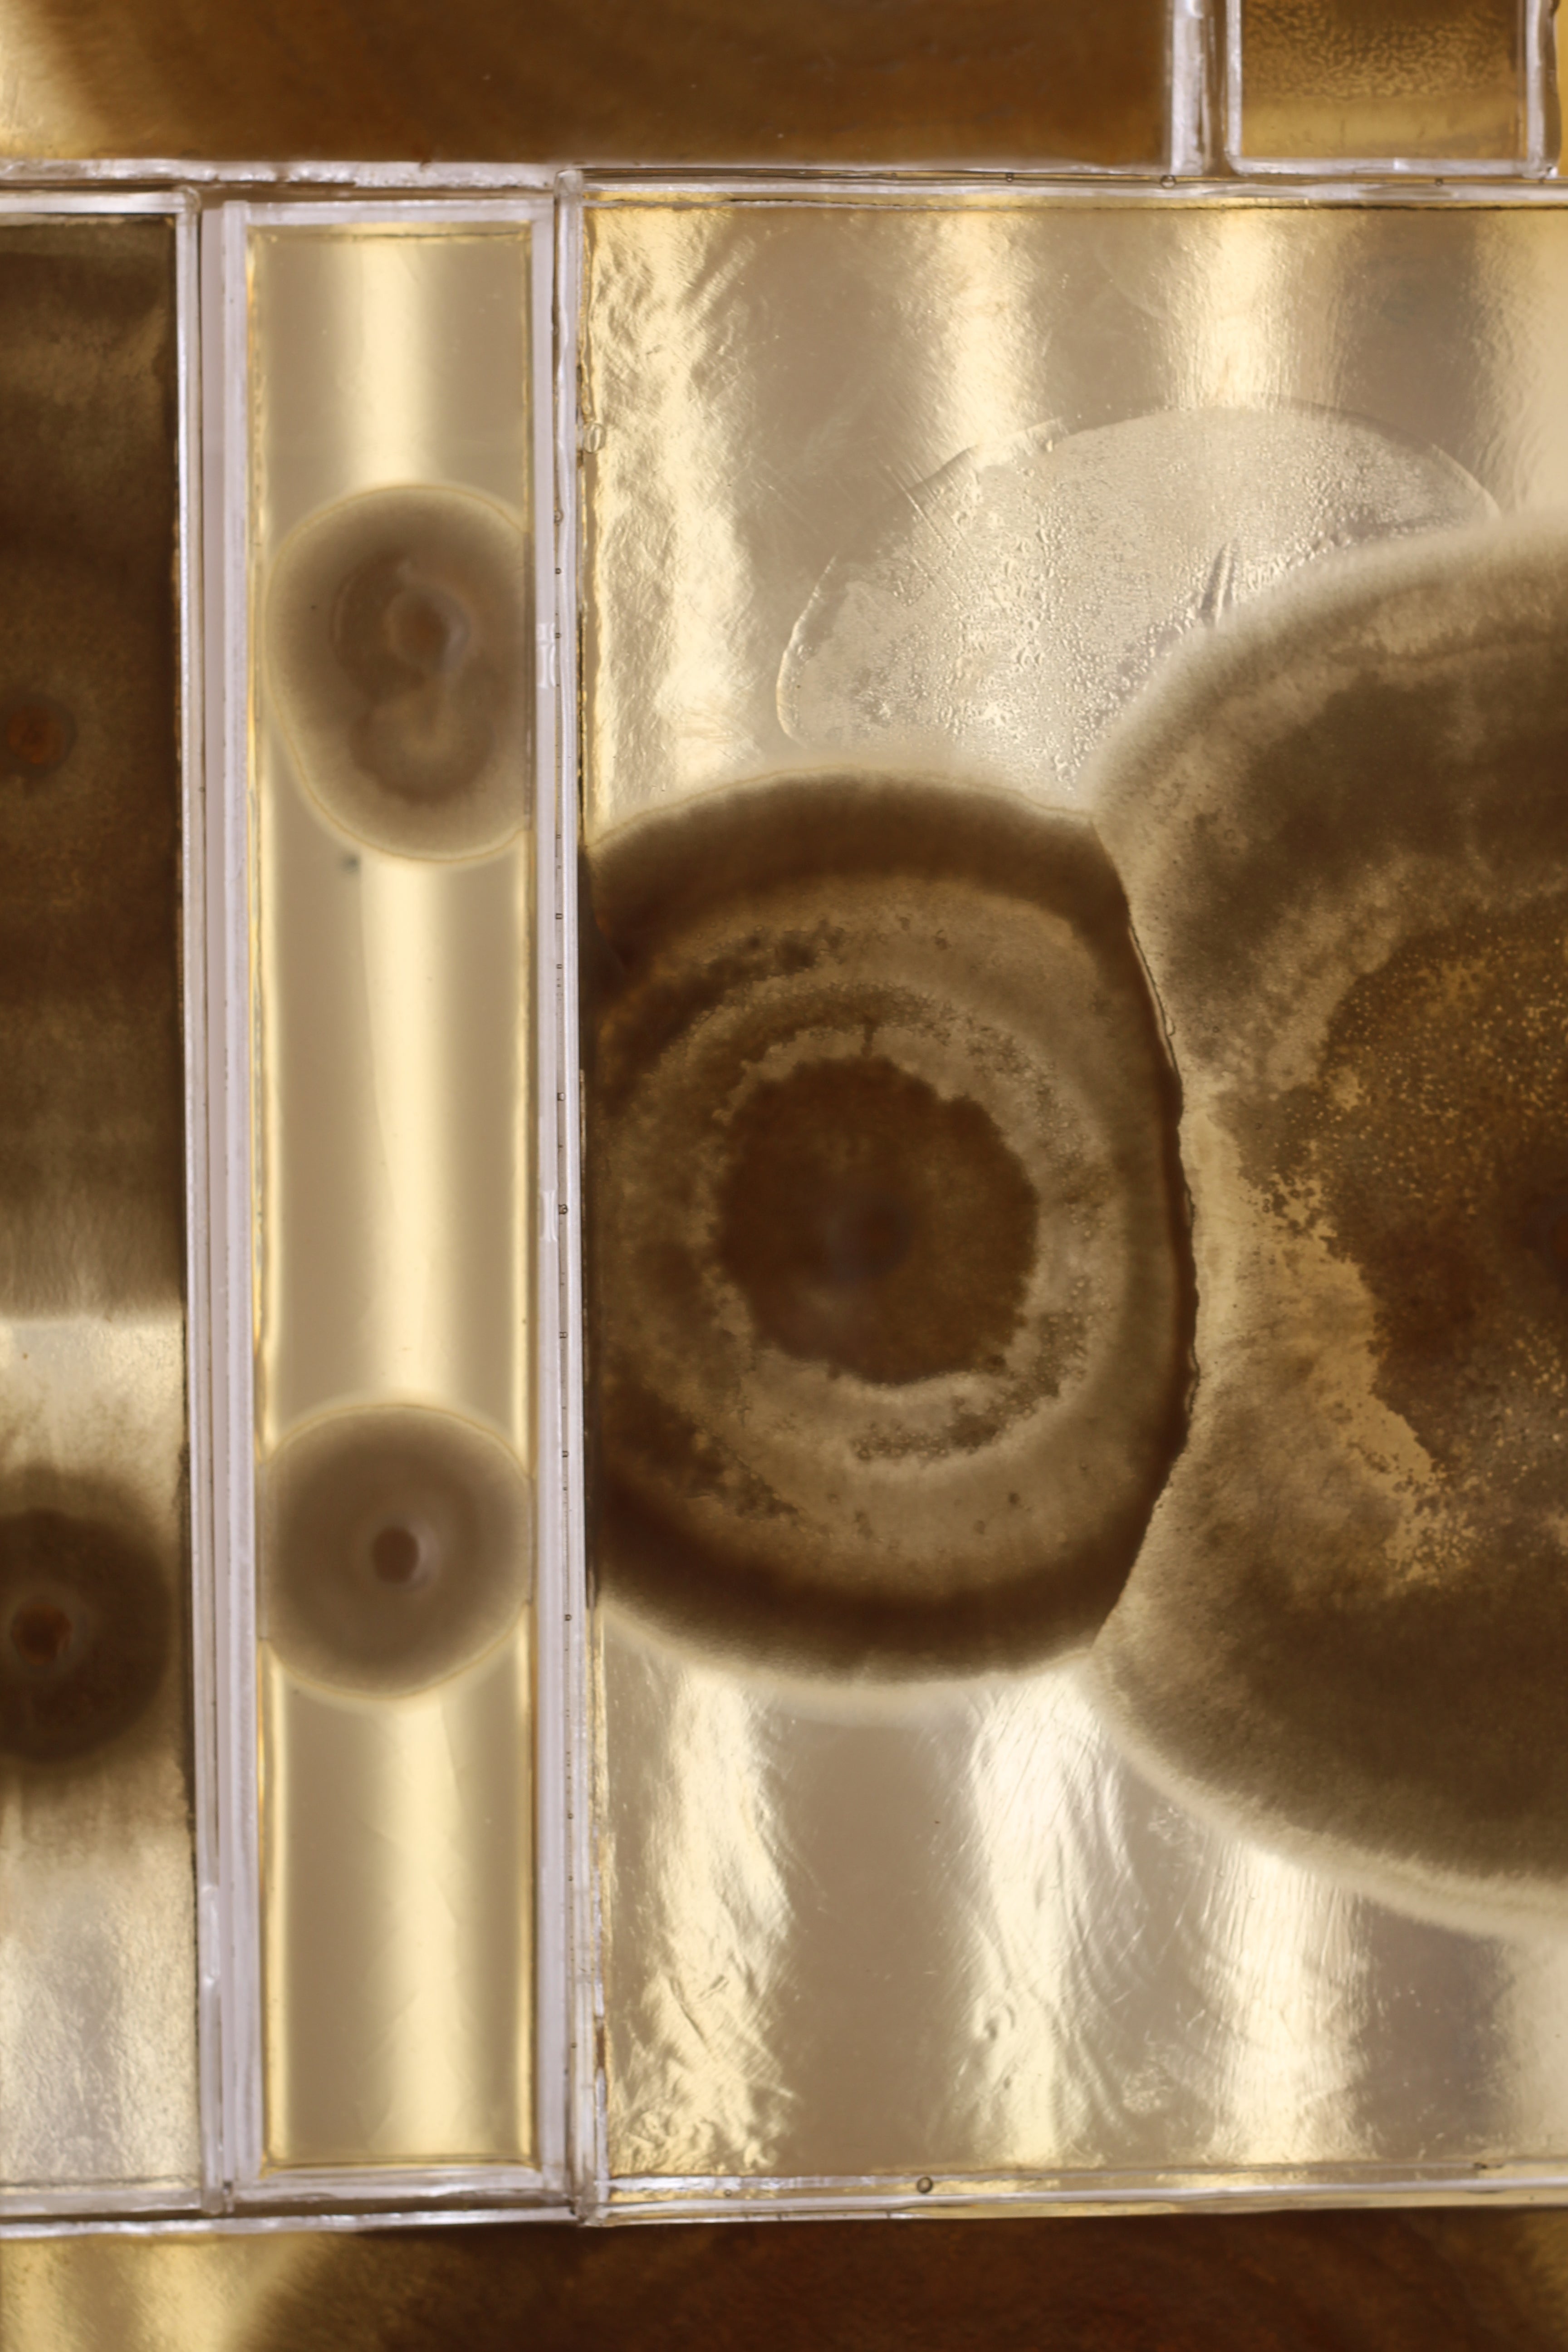
Surface Reflections: Highlights from London Design Biennale 2025

Surface Reflections: Highlights from London Design Biennale 2025
Share article
The London Design Biennale is an international event that showcases cutting-edge design and forward-thinking innovation from around the world. Established in 2016 by Sir John Sorrell CBE and Ben Evans CBE, the Biennale aims to foster collaboration among designers from different countries and demonstrate how design can address global challenges.
This year marks the fifth edition of the event, taking place from June 5–29 at Somerset House. Dr. Samuel Ross MBE serves as the Artistic Director, setting the theme “Surface Reflections,” which invites designers to explore how identity is expressed through design. Over 35 countries are participating, presenting installations and ideas that tackle issues such as urban development, cultural preservation, ecological responsibility, and post-conflict reconstruction.
Here is our pick: Living Assembly: Building with Biology
At this year's London Design Biennale, scientists and designers are demonstrating a future where our buildings and objects aren't manufactured, they're cultivated through biological processes. This convergence of biotechnology and design represents one of the most forward-thinking responses to the Biennale's theme, showing how biological identity can be expressed through living materials that grow, adapt, and respond to their environment. For us, with our deep commitment to working alongside natural systems, this exhibition resonates profoundly with our understanding of how biology and design can collaborate.
When Light Becomes Architecture: Prototree by Northumbria University.
Imagine a tree that grows exactly where the sun tells it to. The Prototree exemplifies phototropic architecture, crafted from bacterial cellulose that microbes synthesise from agricultural waste. Scientists have engineered a dual-organism system, introducing a genetically modified microbe that exhibits phototactic behaviour, producing melanin pigment in response to light gradients and creating patterns across the material as it forms.
Brass branches reach toward the brightest light, ending in leaves made from this responsive bio-material. Each leaf is unique, shaped by the specific light it experienced during the growth phase. This demonstrates architecture that doesn't just sit in a landscape, it actively responds to it.




Stone That Grows: Complex Pringles by Northumbria University
What if we could grow stone in a week instead of waiting millions of years? Using bacteria called Sporosarcina pasteurii, researchers create mineral structures through biology rather than geology. Double-curved frames filled with sand become solid sculptural forms as bacteria precipitate calcium carbonate, the same mineral in limestone.
Each piece emerges from what researchers call "precision-emergence negotiation." Designers set parameters, while bacteria and physics collaborate to determine the final form.




The Intelligence of Mushrooms: Agential Mycelium by Northumbria University
Mycelium networks have been nature's master builders for millions of years. Currently, researchers are studying programming mycelium to grow in specific patterns using light as a guide. These "agential materials" have individual cells that act as environmental sensors that drive macro-scale structural changes.
This suggests applications in building materials that strengthen themselves where stress is detected, or fabrics that adapt based on weather conditions.




Breathing Buildings: Living Morphogenesis by Northumbria University
A bioreactor that grows bacterial cellulose into three-dimensional forms, treating manufacturing as a collaboration between human intent and biological agency. Rather than moulding flat sheets, this system uses controlled aeration to guide cellulose as it forms.
Building Blocks of Tomorrow: Grown Stone Tiles by Cresco Biotech Ltd
Moving from laboratory proof-of-concept to industrial application, Cresco has developed construction tiles made from waste stone bound by microbe-deposited calcium carbonate. It's stone bound by biostone, a potentially carbon-negative process for one of our most carbon-intensive industries. Pilot-scale production facilities are currently in development phases.
Self-Healing Materials: Dirty ELMs by Northumbria University
Perhaps most intriguing are materials that heal themselves. Made from waste like sawdust and hay, enriched with SCOBY (the culture that makes kombucha), these composites can repair damage by growing new bacterial cellulose over wounds. When damaged, the material grows a new skin.


Zero-Energy Movement: BioDynamic Hygroscapes by Northumbria University
Certain bacterial spores naturally expand when humidity changes, an autonomous mechanical response which not require external energy. Research applications harness this to create apertures that automatically open and close in response to moisture, enabling zero-energy ventilation systems for future buildings.


The principles explored in these biodesign innovations, self-healing materials, grown composites from waste substrates, and biodegradable living systems, offer compelling possibilities for sustainable applications across industries. At formerly known as Haeckels, we recognise how these advances in living materials could transform our approach to material choices.
The future isn't being designed through traditional methods—it's being cultivated through bio-integrated processes. This represents a fundamental transformation in material culture that will reshape how we think about sustainability across all applications.
References:
Northumbria University Design Team
Martyn Dade-Robertson, Meng Zhang, Thora Arnardottir, Emily Birch, Katie Gilmour, Jamie Haystead, Aileen Hoenerloh, Dilan Ozkan, Liv Tsim, Fang Zheng, Subhadeep Paul, Mingaile Jackson
UCL Design Team
Richard Beckett, Sean Nair, Aileen Hoenerloh, Arely Leyton Dominguez, Hangchuan Wei, Will Scott, Christopher Whiteside
RC7 Students: Rui Wang, Can Yadimci, Yumo Zhao, Iravati Wagle, Yiming Yao, Qing Wang, Roba Abdelhak, Miruna Porosnicu, Shu Zhang, Ziyi Liu, Wei Zhange, Qingxuan Li, Yoayao Yang, Zhiyuan Wu, Yuchen Lu, Yumeng Wang
Collaborators
Cornell University, Laura Gonzalez
CRESCO Biotech
EM Glass, Charlie and Amelia Burke
APL Workshop, Newcastle University, Oliver Perry
HBBE, Newcastle University
Supporting Bodies
This work has been supported by UK Research and Innovation, including funding from the Engineering and Physical Sciences Research Council (EPSRC), University College London, and Northumbria University


